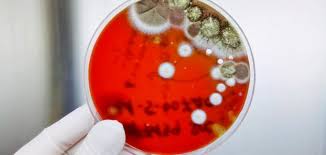

لون البلغم يشير إلى نوع المرض الذي تعانيه.. كيف ذلك؟
بقلم |
محمد جمال حليم |
الاثنين 25 يناير 2021 - 06:00 م
البلغم هو أحد الإفرازات التي تتكون من لعاب ومخاط تصل إلى الفم نتيجة للسعال، حيث إن مصدرها الرئتان.
لون البلغم يبين نوع المرض:
من جانبه يبين الدكتور أحمد أبو النصر أستاذ الطب البديل والعلاج بالنباتات الطبية أن هذا السائل الذي يخرج من الفم لد دلالة على امرض معية تعرف من لون البلغم نفسه.
ويضيف في منشور له على صفحته الرسمية على الفيس بوك أن هذه الألوان أثبتت الأبحاث أنها تبين نوع المرض الذي يعاني منه الشخص فهي ليست "تخمين".
ويوضح د. أبو النصر أنه لو أن البلغم لونه صافي فإن هذا معناه إنك طبيعي والأفضل كل ما يحصل تحاول تخرجه .
أما لو أبيض وسميك يبقى فهذا يدل على أن هناك احتقانًا في الأنف وهذا الأغلب إنه فيه جيوب أنفية، والحل الأمثل ليها نبات السيبرولينا جبار في حل مشاكل الجيوب الأنفية ونزود إننا نستنشق زيت البابونچ ..
أما إذا كان لونه أصفر أو أخضر فإن هذا معناه أن جهازك المناعي داخل في حرب مع الجراثيم أنت لا تعلم عنها شيء ، عايزك تجري على الكركمين والأسكوربيك أسيد ، بكلمك بجد هيحاربوا أي حاجة تضر المناعة ودة في مصلحتك حالياً ..
ويضيف: أما إذا كان لونه أحمر فهذا يدل على سعال شديد جداً لدرجة إنه أمتزج بالدم وهنا تحتاج البازوليا وورق الجوافة ونام في راحة ..
ويكشف أن كل الألوان السابقة لا تقلقك أما إذا كان لونه هو البني أو الأسود حيث يشيثر إلى البني إلى نزيف حصل وما زال موجودا والأسود يعني عدوى فطرية تهاجم المناعة وجسمك مش قادر يقاومها وهنا أنت ممكن تجيلي على طول ..
كيف تتخلص من البلغم بطرق سهلة؟
هناك عدة وسائل يمكنك من خلالها التخلص من البلغم في البيت بداية يلزم معالجة المرض الذي أشار إليه لون البلغم كما مر، إضافة إلى ما يلي: استخدام الماء والسوائل فمن المهم شرب كمية مناسبة من السوائل والماء والحفاظ على رطوبة الجسم، أيضا استنشاق البخار يعد الطريقة الأمثل في علاج البلغم كما أن بإمكانك الاستحمام بالماء الساخن مرتين يوميًا لمدة 10 دقائق للتخلص من البلغم المتراكم، والغرغرة باستخدام الماء المالح يساعد في علاج البلغم، فالماء الدافئ يساعد في التخفيف من هيجان الحلق والبلعوم، أيضا يمتلك عصير الليمون خصائص مضادة للبكتيريا يساعد الجسم في محاربة ومكافحة العدوى التي تسبب تراكم البلغم، وبالتالي علاج البلغم.
ولا يخفى أثر الزنجبيل الرائع في محاربة العدوى في المجاري التنفسية التي سببت تراكم البلغم في المنطقة وعلاج البلغم.








